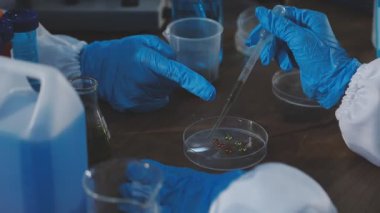
Tıbbi eldivenli bir elin mavi sıvıyla test tüpünü tutarken yakın plan görüntüsü..

İhlal Bildirim Formu
En Çok Aranan Kelimeler
donanıminsanlarSıvıSağlıkİlaç.TıbbiteknolojiDoktorHastaneprofesyonelTest etTüpörnekbiyolojiKimyasalKimyagerDeneyLaboratuvarBilimvirüskimyaaraştırmaanalizBilimselTeknisyenbiyokimyaBiyoteknoloji.bilim adamıMikrobiyolojiBenzer İçerikler